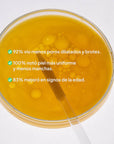
Retinal 0.1% Suero Renovador Avanzado con Niacinamida y Péptidos (30ml) | Ético Skin Lab

Retinal 0.1% Suero Renovador Avanzado con Niacinamida y Péptidos (30ml) | Ético Skin Lab
¿Sabías que el retinaldehído es 11 veces más rápido y 3 veces más potente que el retinol?
Este suero libre de aceite potencia la renovación celular con retinal para suavizar líneas finas, unificar el tono y prevenir imperfecciones. Además, viene enriquecido con:
🧬 Argireline® (Acetyl Hexapeptide-8), el péptido con "efecto botox", estimula la producción de colágeno para una piel más firme y elástica.
🌟 Niacinamida 2%: equilibra el tono y refuerza la barrera cutánea.
💧 Ceramida NP restaura y protege la hidratación natural, dejando la piel suave, luminosa y saludable.
✨ Una fórmula avanzada para transformar tu piel con ciencia y eficacia.
🔸 Apto para todo tipo de piel.
Envase airless opaco que preserva la fórmula y sus antioxidantes en óptimas condiciones.
Marca: Ético Skin Lab
En nuestra tienda, cada producto es libre de crueldad animal, elaborado con prácticas sostenibles y, lo mejor de todo, formulado con ingredientes clínicamente comprobados.🍃🐰
Visítanos en nuestro showroom en el Mall Distrito Avignon, local 9707, sótano 3.
Te esperamos para que pruebes todos los productos que desees y descubras su textura, acabado y cómo se sienten realmente en tu piel.
Encuéntranos en Google Maps.
📍 Estamos abiertos de lunes a viernes, de 10:00 a.m. a 7:00 p.m y sábados de 10:00 a.m. a 2:00 p.m.
¡lanzamos nuestra marca propia!
distribuye ciencia
¿Tienes una tienda de cuidado de la piel, belleza o eres profesional de la salud?
Lanzamos nuestro catálogo al por mayor: entrega skin care comprobado y respaldado a tus clientes.